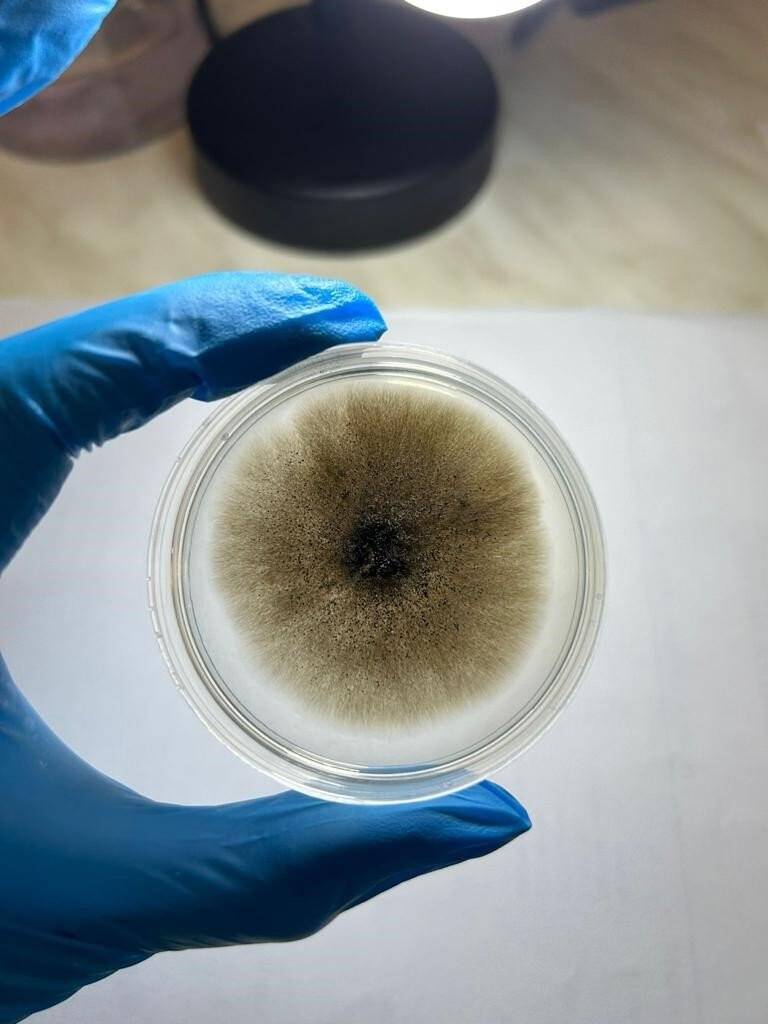
Ölümcül hastalık İstanbul’dan sonra Denizli’de tespit edildi

Ölümcül hastalık İstanbul’dan sonra Denizli’de tespit edildi
Pamukkale Üniversitesi Fen Fakültesi Biyoloji Bölümü Öğretim Üyesi Dr. Refika Ceyda Beram, yüksek lisans öğrencisi Sultan Akyol ile beraber çınar ağaçlarını hasta eden ve ölümcül sonuçlara neden olan hastalığı Denizli'de tespit ederek kayıt altına aldıklarını ifade etti.
Geçtiğimiz yıllarda İstanbul'da tespit edilerek, tarihi çınar ağaçlarının hastalanmasına ve ölümüne neden olan çınar kanseri birçok tartışmaya da neden olmuştu.
Hastalık hakkında bilgi veren Dr. Beram, şunları ifade etti:
"Ceratocystis platani, çınar kanserine neden olan yabancı istilacı bir fungustur. Uluslararası ticaret ve insan faaliyetleri gibi yollarla yeni ortamlara ulaşmakta ve ekosistem üzerinde ciddi tehdit oluşturmaktadır.
BİR ÇOK ÜLKEDE TESPİT EDİLDİ
Çınar türlerinde meydana getirdiği ölümler nedeniyle Avrupa ve Akdeniz Bitki Koruma Örgütünce karantina organizması olarak kabul edilmektedir. Amerika Birleşik Devletlerinde, on binlerce çınar ağacının ölümüne neden olan bu hastalık, Avrupa'da; Arnavutluk, Ermenistan, Fransa, Yunanistan, İtalya ve İsviçre gibi ülkelerde rapor edilmiştir.
İLK ÖNCE İSTANBUL'DA GÖRÜLDÜ
Türkiye'de daha önce sadece İstanbul'da tespit edilen bu iletim demeti hastalığını, Denizli'de bir çınarın rüzgar sonrası kırılarak devrilmesi sonucunda tespit ettik.
Bu kanserin Denizli'de tespit edilmiş olması, patojenin yayılışının endişe verici düzeyde olduğunun bir işaretidir. Hastalık Türkiye'nin batısında bulunan diğer şehirlerde de yayılmaya başlamış olabilir. Bu kayıt Türkiye'de gelecekte çınarların ne denli büyük bir tehdit altında olabileceğinin önemli bir göstergesidir.
CAN KAYBINA DA SEBEP OLABİLİR
Devrilen bu ağaçlar maddi hasara neden olmasının yanı sıra can kayıplarına da sebep olabilmektedir" diyen Beram, şöyle konuştu: "Erken tanı her alanda olduğu gibi bitki hastalıklarının tespitinde de çok önemli bir rol üstlenmektedir. Dışardan sağlıklı gibi görünen birçok ağaçta bu gibi önemli problemler bulunmaktadır. Hastalık belirtisi göstermeyen ağaçlara tamamen sağlıklı diyemeyiz. Sağlıklı görünen ağaçların kısa süre içinde hastalık etmeni nedeniyle etkilenmeyeceğinin ve devrilmeyeceğinin hiçbir garantisi yoktur."

Kaynak:İhlas Haber Ajansı
Türkçe karakter kullanılmayan yorumlar onaylanmamaktadır.